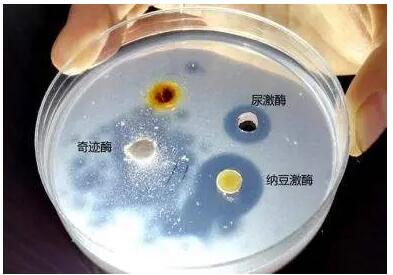

一提到糖,人们往往联想到吃的红糖,白糖、水果糖等,其实人每天所吃的食物中约有80%是糖类。人体活动所需要的能量,在正常生理情况下,约70%是由糖提供的。食物中的糖类主要是淀粉,有时还有少量蔗糖和乳糖等。
淀粉是一种多糖,是由许多葡萄糖分子组成的。蔗糖和乳糖均属于双糖,是由二分子单糖组成的。常见的多糖、双糖、单糖有:
多糖:淀粉、糖元
双糖:麦芽糖→葡萄糖+葡萄糖;蔗糖→果糖+葡萄糖;乳糖→牛乳糖+葡萄糖
单糖:葡萄糖、果糖,牛乳糖
吸收进人体内的单糖主要是葡萄糖,少量的果糖和牛乳糖被吸收以后,在肝内也几乎全部转变成葡萄糖,所以体内糖的代谢,实际上是以葡萄糖代谢为中心的。血液中所含的糖主要是葡萄糖,简称血糖。正常人早晨空腹时,每100毫升静脉血液含葡萄糖为80~120毫克(80~120毫克%)。在种经和体液因素的调节下,使糖的来源和去路维持平衡。
血糖的来源主要有三条:(1)食物中的糖经过消化后吸收。如大米、面粉中的淀粉,经过消化变成葡萄糖而被吸收。(2)肝糖元分解。贮存在肝中的糖元又称为动物淀粉,分解后可变成许多分子的葡萄糖。如在饥饿时,肝糖元便分解为葡萄糖。(3)糖元异生。一些非糖物质,如乳酸、脂肪中的甘油和蛋白质中的某些氨基酸等,在肝中可以转变成肝糖元,此过程叫糖元异生。如酸中毒的病人,常输乳酸钠,因为乳酸钠在体内分解成乳酸和钠,乳酸可经糖元异生变成肝糖元,而钠与血中的碳酸根(HCO3-)结合变成碳酸氢钠(NaHCO3),是一种碱性物质,可中和酸,纠正酸中毒。
血糖的去路主要也有三条:(1)葡萄糖在体内被氧化,放出能量,供人体利用,这是血糖的主要去路。(2)合成肝糖元和肌糖元。如饭后,由于葡萄糖吸收入血,血糖浓度高于正常含量,这时葡萄糖在肝脏和肌肉中合成肝糖元和肌糖元,贮存起来,血糖浓度又降到正常。(3)转变成非糖物质。如变成甘油、脂肪酸和某些氨基酸等。这就是食人的糖过剩而在体内可以脂肪的形式贮存起来,使人变胖的一个原因。血糖来源和去路动态平衡的维持,保持了血糖相对的恒定。如这种平衡被打破,使血糖的含量于空腹时持续在130毫克%以上,就称为高血糖。如血糖超过了160毫克%时,尿中可发现葡萄糖,称为糖尿,常见于糖尿病患者。







